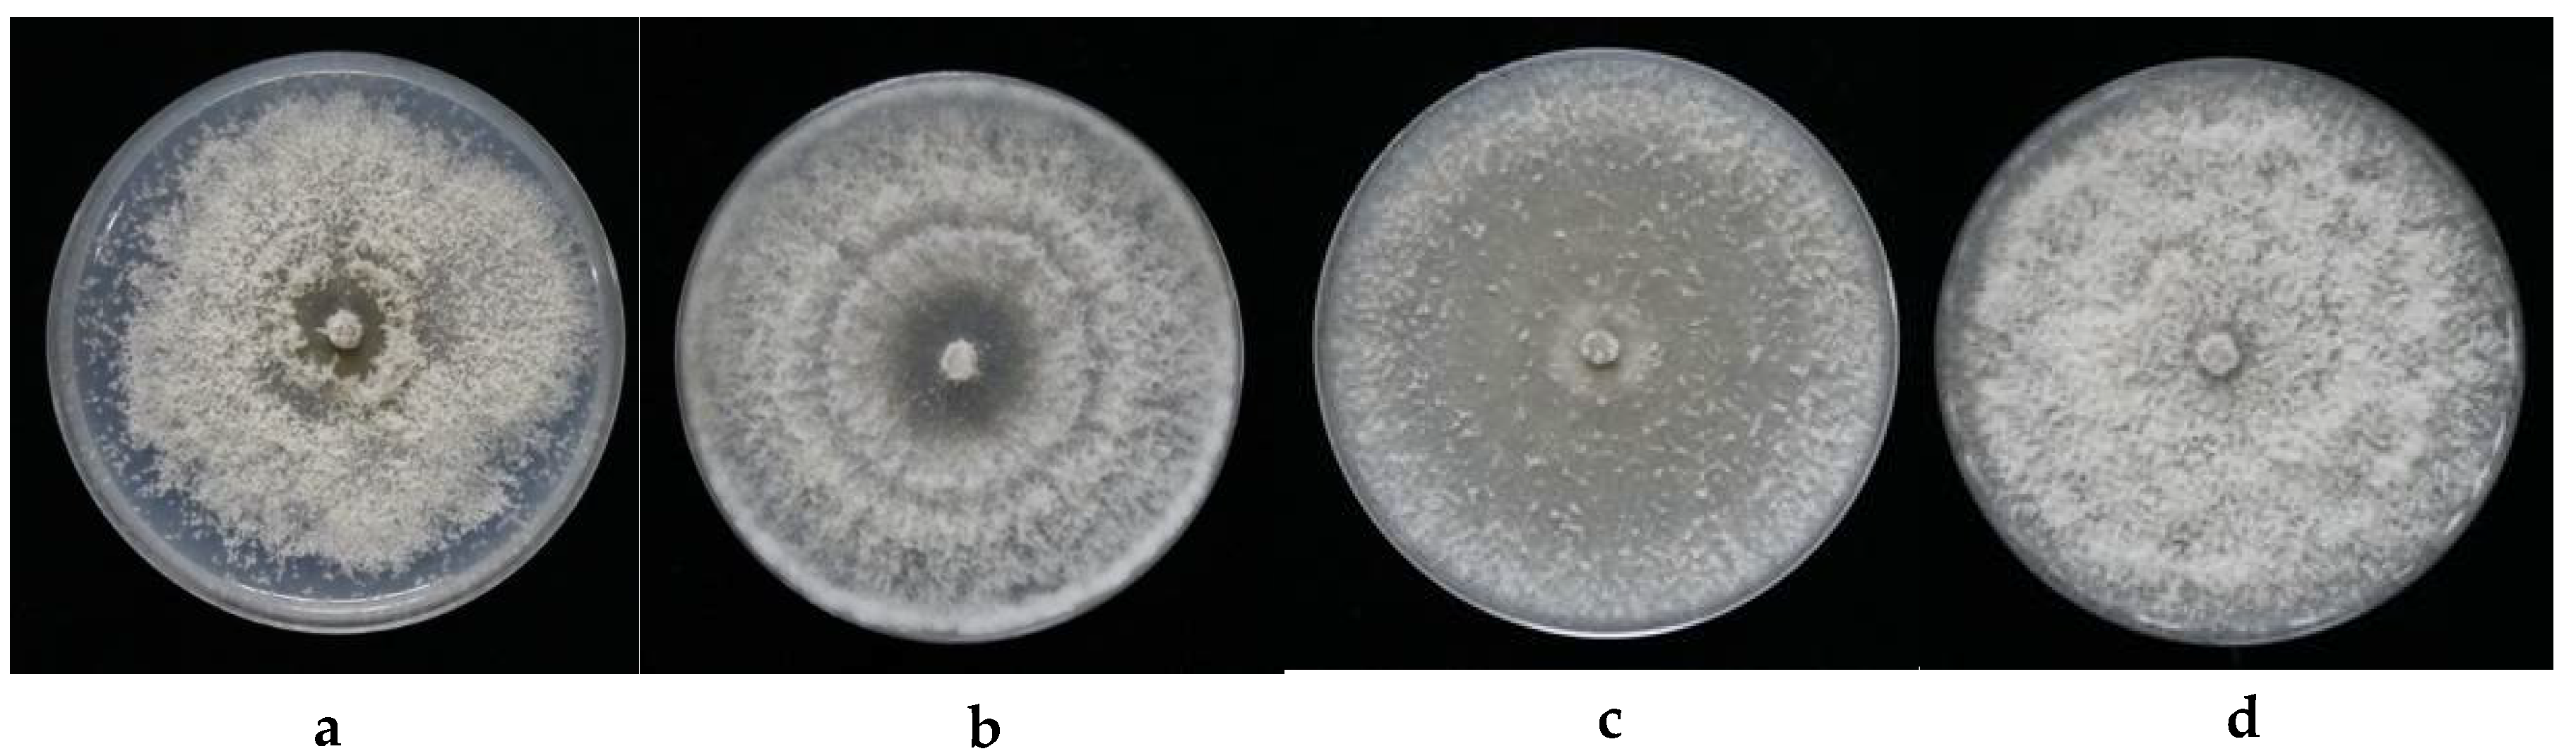

Antifungal Activities of Volatile Secondary Metabolites of Four Diaporthe Strains Isolated from Catharanthus roseus
Abstract
1. Introduction
2. Materials and Methods
2.1. Endophytic Fungal Isolation
2.2. DNA Extraction, PCR, and Sequencing
2.3. Sequence Alignment and Phylogenetic Analysis
2.4. Antifungal Activity Tests for Fungal VOCs
2.5. Qualitative Analyses on Volatiles of the Four Endophytic Cultures
3. Results
3.1. The Identification on the Four Endophytic Isolates within the Diaporthe Genus
3.2. The VOCs’ Bioactivities of the Four Diaporthe Strains against Plant Fungal Pathogens
3.3. The Qualification on VOCs of the Four Endophytic Diaporthe Strains
4. Discussion
4.1. Endophytic Diaporthe spp. from Catharanthus roseus
4.2. VOCs Antifungal Effects of Endophytic Diaporthe spp. from Catharanthus roseus
Supplementary Materials
Author Contributions
Acknowledgments
Conflicts of Interest
References
- Kumar, G.; Chandra, P.; Choudhary, M. Endophytic fungi: A potential source of bioactive compounds. Chem. Sci. Rev. Lett. 2017, 6, 2373–2381. [Google Scholar]
- Goyal, P.; Khanna, A.; Chauhan, A.; Chauhan, G.; Kaushik, P. In vitro evaluation of crude extracts of Catharanthus roseus for potential antibacterial activity. Int. J. Green Pharm. 2008, 2, 178–181. [Google Scholar] [CrossRef]
- Ramya, S.; Govindaraji, V.; Kannan, K.N.; Jayakumararaj, R. In vitro evaluation of antibacterial activity using crude extracts of Catharanthus roseus L. (G.) Don. Ethnobot. Leafl. 2008, 12, 1067–1072. [Google Scholar]
- Kabesh, K.; Senthilkumar, P.; Ragunathan, R.; Kumar, R.R. Phytochemical analysis of Catharanthus roseus plant extract and its antimicrobial activity. Int. J. Pure Appl. Biosci. 2015, 3, 162–172. [Google Scholar]
- Patil, P.J.; Ghosh, J.S. Antimicrobial activity of Catharanthus roseus—A detailed study. Br. J. Pharmacol. Toxicol. 2010, 1, 40–44. [Google Scholar]
- Hanafy, M.; Matter, M.; Asker, M.; Rady, M. Production of indole alkaloids in hairy root cultures of Catharanthus roseus l. and their antimicrobial activity. S. Afr. J. Bot. 2016, 105, 9–18. [Google Scholar] [CrossRef]
- Lakra, N.S.; Koul, M.; Chandra, R.; Chandra, S. Histological investigations of healthy tissues of Catharanthus roseus to localize fungal endophytes. Int. J. Pharm. Sci. Rev. Res. 2013, 20, 205–209. [Google Scholar]
- Pandey, S.S.; Singh, S.; Babu, C.S.V.; Shanker, K.; Srivastava, N.K.; Shukla, A.K.; Kalra, A. Fungal endophytes of Catharanthus roseus enhance vindoline content by modulating structural and regulatory genes related to terpenoid indole alkaloid biosynthesis. Sci. Rep. 2016, 6, 26583. [Google Scholar] [CrossRef] [PubMed]
- Shi, Y.; Zhou, M.; Tang, Z.; Rao, L. Isolation and identification on endophytic fungus from Catharanthus roseus. J. Anhui Agric. Sci. 2008, 36, 12712–12713. [Google Scholar] [CrossRef]
- Akpotu, M.O.; Eze, P.M.; Abba, C.C.; Umeokoli, B.O.; Nwachukwu, C.U.; Okoye, F.B.C.; Esimone, C.O. Antimicrobial activities of secondary metabolites of endophytic fungi isolated from Catharanthus roseus. J. Health Sci. 2017, 7, 15–22. [Google Scholar] [CrossRef]
- Nair, D.N.; Padmavathy, S. Impact of endophytic microorganisms on plants, environment and humans. Sci. World J. 2014, 2014. [Google Scholar] [CrossRef] [PubMed]
- Santos, P.J.C.D.; Savi, D.C.; Gomes, R.R.; Goulin, E.H.; Senkiv, C.D.C.; Tanaka, F.A.O.; Almeida, Á.M.R.; Galli-Terasawa, L.; Kava, V.; Glienke, C. Diaporthe endophytica and D. terebinthifolii from medicinal plants forbiological control of Phyllosticta citricarpa. Microbiol. Res. 2016, 186, 153–160. [Google Scholar] [CrossRef] [PubMed]
- Tonial, F.; Maia, B.H.L.N.S.; Sobottka, A.M.; Savi, D.C.; Vicente, V.A.; Gomes, R.R.; Glienke, C. Biological activity of Diaporthe terebinthifolii extracts against Phyllosticta citricarpa. FEMS Microbiol. Lett. 2017, 364. [Google Scholar] [CrossRef] [PubMed]
- Tanapichatsakul, C.; Monggoot, S.; Gentekaki, E.; Pripdeevech, P. Antibacterial and antioxidant metabolites of Diaporthe spp. Isolated from flowers of Melodorum fruticosum. Curr. Microbiol. 2017, 75, 476–483. [Google Scholar] [CrossRef] [PubMed]
- Rakshith, D.; Santosh, P.; Satish, S. Isolation and characterization of antimicrobial metabolite producing endophytic Phomopsis sp. from Ficus pumila Linn. (Moraceae). Int. J. Chem. Anal. Sci. 2013, 4, 156–160. [Google Scholar] [CrossRef]
- Chepkirui, C.; Stadler, M. The genus Diaporthe: A rich source of diverse and bioactive metabolites. Mycol. Prog. 2017, 16, 477–494. [Google Scholar] [CrossRef]
- Strobel, G.A.; Dirkse, E.; Sears, J.; Markworth, C. Volatile antimicrobials from Muscodor albus, a novel endophytic fungus. Microbiology 2001, 147, 2943–2950. [Google Scholar] [CrossRef] [PubMed]
- Singh, S.K.; Strobel, G.A.; Knighton, B.; Geary, B.; Sears, J.; Ezra, D. An endophytic Phomopsis sp. possessing bioactivity and fuel potential with its volatile organic compounds. Microb. Ecol. 2011, 61, 729–739. [Google Scholar] [CrossRef] [PubMed]
- Qadri, M.; Deshidi, R.; Shah, B.A.; Bindu, K.; Vishwakarma, R.A.; Riyaz-Ul-Hassan, S. An endophyte of Picrorhiza kurroa Royle ex. Benth, producing menthol, phenylethyl alcohol and 3-hydroxypropionic acid, and other volatile organic compounds. World J. Microbiol. Biotechnol. 2015, 31, 1647–1654. [Google Scholar] [CrossRef] [PubMed]
- Wang, K.; Strobel, G.; Yan, D.-H. The production of 1,8-cineole, a potential biofuel, from an endophytic strain of Annulohypoxylon sp. FPYF3050 when grown on agricultural residues. J. Sustain. Bioenergy Syst. 2017, 7, 65–84. [Google Scholar] [CrossRef][Green Version]
- White, T.J.; Bruns, T.D.; Lee, S.B.; Taylor, J.W.; Innis, M.A.; Gelfand, D.H.; Sninsky, J.J. Amplification and direct sequencing of fungal ribosomal rnagenes for phylogenetics. PCR Protoc. A Guide Methods Appl. 1990, 18, 315–322. [Google Scholar] [CrossRef]
- Alves, A.; Crous, P.; Correia, A.; Phillips, A. Morphological and molecular data reveal cryptic species in Lasiodiplodia theobromae. Fungal Divers. 2008, 28, 1–13. [Google Scholar]
- Santos, L.; Alves, A.; Alves, R. Evaluating multi-locus phylogenies for species boundaries determination in the genus Diaporthe. PeerJ 2017, 5, e3120. [Google Scholar] [CrossRef] [PubMed]
- Glass, N.; Donaldson, G. Development of primer sets designed for use with the PCR to amplify conserved genes from filamentous ascomycetes. Appl. Environ. Microbiol. 1995, 61, 1323–1330. [Google Scholar] [PubMed]
- O’Donnell, K.; Cigelnik, E. Two divergent intragenomic rDNA ITS2 types within a monophyletic lineage of the fungus Fusarium arenonorthologous. Mol. Phylogenet. Evol. 1997, 7, 103–116. [Google Scholar] [CrossRef] [PubMed]
- Udayanga, D.; Castlebury, L.A.; Rossman, A.Y.; Chukeatirote, E.; Hyde, K.D. Insights into the genus Diaporthe: Phylogenetic species delimitation in the D. eres species complex. Fungal Divers. 2014, 67, 203–229. [Google Scholar] [CrossRef]
- Katoh, K.; Standley, D.M. Mafft multiple sequence alignment software version 7: Improvements in performance and usability. Mol. Biol. Evol. 2013, 30, 772–780. [Google Scholar] [CrossRef] [PubMed]
- Lanfear, R.; Frandsen, P.B.; Wright, A.M.; Senfeld, T.; Calcott, B. Partitionfinder 2: New methods for selecting partitioned models of evolution for molecular and morphological phylogenetic analyses. Mol. Biol. Evol. 2017, 34, 772–773. [Google Scholar] [CrossRef] [PubMed]
- Vaidya, G.; Lohman, D.; Meier, R. Sequencematrix: Concatenation software for the fast assembly of multi-gene datasets with character set and codon information. Cladistics 2011, 27, 171–180. [Google Scholar] [CrossRef]
- Tamura, K.; Stecher, G.; Peterson, D.; Filipski, A.; Kumar, S. Mega6: Molecular evolutionary genetics analysis version 6.0. Mol. Biol. Evol. 2013, 30, 2725–2729. [Google Scholar] [CrossRef] [PubMed]
- Stöver, B.C.; Müller, K.F. Treegraph 2: Combining and visualizing evidence from different phylogenetic analyses. BMC Bioinform. 2010, 11, 7. [Google Scholar] [CrossRef] [PubMed]
- Ayob, F.W.; Simarani, K. Endophytic filamentous fungi from a Catharanthus roseus: Identification and its hydrolytic enzymes. Saudi Pharm. J. 2016, 24, 273–278. [Google Scholar] [CrossRef] [PubMed]
- Momsia, P.; Momsia, T. Isolation, frequency distribution and diversity of novel fungal endophytes inhabiting leaves of Catharanthus roseus. Int. J. Life Sci. Biotechnol. Pharm. Res. 2013, 2, 82–87. [Google Scholar]
- Kharwar, R.N.; Verma, V.C.; Strobel, G.; Ezra, D. The endophytic fungal complex of Catharanthus roseus (L.) g. Don. Curr. Sci. 2008, 95, 228–233. [Google Scholar] [CrossRef]
- Manogaran, S.; Kannan, K.P.; Mathiyalagan, Y. Fungal endophytes from Phyllanthus acidus (L.) and Catharanthus roseus (L.). Int. Res. J. Pharm. 2017, 8, 86–89. [Google Scholar] [CrossRef]
- Srinivasan, K.; Muthumary, J. Taxol production from Pestalotiopsis sp an endophytic fungus isolated from Catharanthus roseus. J. Ecobiotechnol. 2009, 1, 28–31. [Google Scholar]
- Palem, P.P.C.; Kuriakose, G.C.; Jayabaskaran, C. An endophytic fungus, Talaromyces radicus, isolated from catharanthus roseus, produces vincristine and vinblastine, which induce apoptotic cell death. PLoS ONE 2015, 10, e0144476. [Google Scholar] [CrossRef] [PubMed]
- Ayob, F.W.; Simarani, K.; Abidin, N.Z.; Mohamad, J. First report on a novel nigrospora sphaerica isolated from Catharanthus roseus plant with anticarcinogenic properties. Microb. Biotechnol. 2017, 10, 926–932. [Google Scholar] [CrossRef] [PubMed]
- Rakotoniriana, E.F.; Chataigné, G.; Raoelison, G.; Rabemanantsoa, C.; Munaut, F.; El Jaziri, M.; Urveg-Ratsimamanga, S.; Marchand-Brynaert, J.; Corbisier, A.-M.; Declerck, S.; et al. Characterization of an endophytic whorl-forming Streptomyces from Catharanthus roseus stems producing polyene macrolide antibiotic. Can. J. Microbiol. 2012, 58, 617–627. [Google Scholar] [CrossRef] [PubMed]
- Singh, D.; Rathod, V.; Singh1, A.K.; Haq, M.U.; Mathew, J.; Kulkarni, P. A study on extracellular synthesis of silver nanoparticles from endophytic fungi, isolated from ethanomedicinal plants Curcuma longa and Catharanthus roseus. Int. Lett. Nat. Sci. 2016, 57, 58–66. [Google Scholar] [CrossRef]
- Tickoo, M.; Farooq, U.; Bhatt, N.; Dhiman, M.; Alam, A.; Khan, M.A.; Jaglan, S. Alterneriol: Secondary metabolites derived from endophytic fungi Alternaria spp. isolated from Catharanthus roseus. UJPAH 2015, 1, 15–17. [Google Scholar]
- Tang, Z.; Rao, L.; Peng, G.; Zhou, M.; Shi, G.; Liang, Y. Effects of endophytic fungus and its elicitors on cell status and alkaloid synthesis in cell suspension cultures of Catharanthus roseus. J. Med. Plants Res. 2011, 5, 2192–2200. [Google Scholar]
- Sunitha, V.H.; Devi, D.N.; Srinivas, C. Extracellular enzymatic activity of endophytic fungal strains isolated from medicinal plants. World J. Agric. Sci. 2013, 9, 01–09. [Google Scholar] [CrossRef]
- Roy, S.; Banerjee, D. Broad spectrum antibacterial activity of granaticinic acid, isolated from Streptomyces thermoviolaceus NT1; an endophyte in Catharanthus roseus (L.) G. Don. J. Appl. Pharm. Sci. 2015, 5, 006–011. [Google Scholar] [CrossRef]
- De Pinho, P.G.; Goncalves, R.F.; Valent, P.; Pereira, D.M.; Seabra, R.M.; Andrade, P.B.; Sottomayor, M. Volatile composition of Catharanthus roseus (L.) G. Don using solid-phase microextraction and gas chromatography/mass spectrometry. J. Pharm. Biomed. Anal. 2009, 49, 674–685. [Google Scholar] [CrossRef] [PubMed]
- Aziz, S.; Saha, K.; Sultana, N.; Khan, M.; Nada, K.; Afroze, M. Comparative studies of volatile components of the essential oil of leaves and flowers of Catharanthus roseus growing in bangladesh by GC-MS analysis. Indian J. Pharm. Biol. Res. 2015, 3, 6–10. [Google Scholar] [CrossRef]
- Bier, M.C.J.; Medeiros, A.B.P.; Soccol, C.R. Biotransformation of limonene by an endophytic fungus using synthetic and orange residue-based media. Fungal Biol. 2017, 121, 137–144. [Google Scholar] [CrossRef] [PubMed]
- Bertrand, S.; Schumpp, O.; Bohni, N.; Monod, M.; Gindro, K.; Wolfender, J.-L. De novo production of metabolites by fungal co-culture of Trichophyton rubrum and Bionectria ochroleuca. J. Nat. Prod. 2013, 76, 1157–1165. [Google Scholar] [CrossRef] [PubMed]
- Dickschat, J.S. Fungal volatiles—A survey from edible mushrooms to moulds. Nat. Prod. Rep. 2017, 34, 310–328. [Google Scholar] [CrossRef] [PubMed]
- Garzoli, S.; Božović, M.; Baldisserotto, A.; Sabatino, M.; Cesa, S.; Pepi, F.; Vicentini, C.B.; Manfredini, S.; Ragno, R. Essential oil extraction, chemical analysis and anti-candida activity of Foeniculum vulgare miller—New approaches. Nat. Prod. Res. 2018, 32, 1254–1259. [Google Scholar] [CrossRef] [PubMed]
- Dai, J.; Zhu, L.; Yang, L.; Qiu, J. Chemical composition, antioxidant and antimicrobial activities of essential oil from Wedelia prostrata. EXCLI J. 2013, 12, 479–490. [Google Scholar] [CrossRef] [PubMed]
- Cosge, B.; Turker, A.; Ipek, A.; Gurbuz, B.; Arslan, N. Chemical compositions and antibacterial activities of the essential oils from aerial parts and corollas of Origanum acutidens (Hand.-Mazz.) Ietswaart, an endemic species to turkey. Molecules 2009, 14, 1702–1712. [Google Scholar] [CrossRef] [PubMed]
- Espinosa-García, F.J.; Langenheim, J.H. Effects of sabinene and γ-terpinene from coastal redwood leaves acting singly or in mixtures on the growth of some of their fungus endophytes. Biochem. Syst. Ecol. 1991, 19, 643–650. [Google Scholar] [CrossRef]
- Verma, R.S.; Joshi, N.; Padalia, R.C.; Singh, V.R.; Goswami, P.; Verma, S.K.; Iqbal, H.; Chanda, D.; Verma, R.K.; Darokar, M.P.; et al. Chemical composition and antibacterial, antifungal, allelopathic and acetylcholinesterase inhibitory activities of cassumunar-ginger. J. Sci. Food Agric. 2018, 98, 321–327. [Google Scholar] [CrossRef] [PubMed]
- Rachitha, P.; Krupashree, K.; Jayashree, G.; Gopalan, N.; Khanum, F. Growth inhibition and morphological alteration of Fusarium sporotrichioides by Mentha piperita essential oil. Pharmacogn. Res. 2017, 9, 74–79. [Google Scholar] [CrossRef]
- Moghaddam, M.; Pourbaige, M.; Tabar, H.K.; Farhadi, N.; Hosseini, S.M.A. Composition and antifungal activity of peppermint (Mentha piperita) essential oil from Iran. J. Essent. Oil Bear. Plants 2013, 16, 506–512. [Google Scholar] [CrossRef]
- Strobel, G. The story of mycodiesel. Curr. Opin. Microbiol. 2014, 19, 52–58. [Google Scholar] [CrossRef] [PubMed]

| Isolate | ITS | TEF1 | Tublin | CAL | HIS |
|---|---|---|---|---|---|
| FPYF3053 | MH203054.1 | MH220826.1 | MH220836.1 | MH220831.1 | MH220839.1 |
| FPYF3054 | MH203055.1 | MH220827.1 | MH220833.1 | MH220832.1 | MH220840.1 |
| FPYF3055 | MH203056.1 | MH220828.1 | MH220834.1 | MH220829.1 | MH220837.1 |
| FPYF3056 | MH203057.1 | MH220825.1 | MH220835.1 | MH220830.1 | MH220838.1 |
| Source | ITS | TEF1 | TUB | CAL | HIS |
|---|---|---|---|---|---|
| Diaporthe acaciigena_CBS 129521 | KC343005.1 | KC343731.1 | KC343973.1 | KC343247.1 | KC343489.1 |
| Diaporthe acerina_CBS 137.27 | KC343006.1 | KC343732.1 | KC343974.1 | KC343248.1 | KC343490.1 |
| Diaporthe alleghaniensis_CBS 495.72 | KC343007.1 | KC343733.1 | KC343975.1 | KC343249.1 | KC343491.1 |
| Diaporthe alnea_CBS 146.46 | KC343008.1 | KC343734.1 | KC343976.1 | KC343250.1 | KC343492.1 |
| Diaporthe alnea_CBS 159.47 | KC343009.1 | KC343735.1 | KC343977.1 | KC343251.1 | KC343493.1 |
| Diaporthe ambigua_CBS 114015 | KC343010.1 | KC343736.1 | KC343978.1 | KC343252.1 | KC343494.1 |
| Diaporthe ambigua_CBS 117167 | KC343011.1 | KC343737.1 | KC343979.1 | KC343253.1 | KC343495.1 |
| Diaporthe amygdali_CBS 126679 | KC343022.1 | KC343742.1 | KC343984.1 | KC343258.1 | KC343506.1 |
| Diaporthe ampelina_CBS 111888 | KC343016.1 | KC343748.1 | KC343990.1 | KC343264.1 | KC343500.1 |
| Diaporthe amygdali_CBS 111811 | KC343019.1 | KC343745.1 | KC343987.1 | KC343261.1 | KC343503.1 |
| Diaporthe anacardii_CBS 720.97 | KC343024.1 | KC343750.1 | KC343992.1 | KC343266.1 | KC343508.1 |
| Diaporthe angelicae_CBS 111592 | KC343027.1 | KC343753.1 | KC343995.1 | KC343269.1 | KC343511.1 |
| Diaporthe angelicae_CBS 123215 | KC343028.1 | KC343754.1 | KC343996.1 | KC343270.1 | KC343512.1 |
| Diaporthe cucurbitae_CBS 136.25 | KC343031.1 | KC343757.1 | KC343999.1 | KC343273.1 | KC343515.1 |
| Diaporthe arecae_CBS 161.64 | KC343032.1 | KC343758.1 | KC344000.1 | KC343274.1 | KC343516.1 |
| Diaporthe arecae_CBS 535.75 | KC343033.1 | KC343759.1 | KC344001.1 | KC343275.1 | KC343517.1 |
| Diaporthe arengae_CBS 114979 | KC343034.1 | KC343760.1 | KC344002.1 | KC343276.1 | KC343518.1 |
| Diaporthe aspalathi_CBS 117169 | KC343036.1 | KC343762.1 | KC344004.1 | KC343278.1 | KC343520.1 |
| Diaporthe aspalathi_CBS 117168 | KC343035.1 | KC343761.1 | KC344003.1 | KC343277.1 | KC343519.1 |
| Diaporthe australafricana_CBS 111886 | KC343038.1 | KC343764.1 | KC344006.1 | KC343280.1 | KC343522.1 |
| Diaporthe australafricana_CBS 113487 | KC343039.1 | KC343765.1 | KC344007.1 | KC343281.1 | KC343523.1 |
| Diaporthe batatas_CBS 122.21 | KC343040.1 | KC343766.1 | KC344008.1 | KC343282.1 | KC343524.1 |
| Diaporthe beckhausii_CBS 138.27 | KC343041.1 | KC343767.1 | KC344009.1 | KC343283.1 | KC343525.1 |
| Diaporthe bicincta_CBS 121004 | KC343134.1 | KC343860.1 | KC344102.1 | KC343376.1 | KC343618.1 |
| Diaporthe brasiliensis_CBS 133183 | KC343042.1 | KC343768.1 | KC344010.1 | KC343284.1 | KC343526.1 |
| Diaporthe brasiliensis_LGMF926 | KC343043.1 | KC343769.1 | KC344011.1 | KC343285.1 | KC343527.1 |
| Diaporthe carpini_CBS 114437 | KC343044.1 | KC343770.1 | KC344012.1 | KC343286.1 | KC343528.1 |
| Diaporthe caulivora_CBS 127268 | KC343045.1 | KC343771.1 | KC344013.1 | KC343287.1 | KC343529.1 |
| Diaporthe caulivora_CBS 178.55 | KC343046.1 | KC343772.1 | KC344014.1 | KC343288.1 | KC343530.1 |
| Diaporthe celastrina_CBS 139.27 | KC343047.1 | KC343773.1 | KC344015.1 | KC343289.1 | KC343531.1 |
| Diaporthe chamaeropis_CBS 454.81 | KC343048.1 | KC343774.1 | KC344016.1 | KC343290.1 | KC343532.1 |
| Diaporthe chamaeropis_CBS 753.70 | KC343049.1 | KC343775.1 | KC344017.1 | KC343291.1 | KC343533.1 |
| Diaporthe cinerascens_CBS 719.96 | KC343050.1 | KC343776.1 | KC344018.1 | KC343292.1 | KC343534.1 |
| Diaporthe citri_CBS 199.39 | KC343051.1 | KC343777.1 | KC344019.1 | KC343293.1 | KC343535.1 |
| Diaporthe citri_CBS 230.52 | KC343052.1 | KC343778.1 | KC344020.1 | KC343294.1 | KC343536.1 |
| Diaporthe convolvuli_CBS 124654 | KC343054.1 | KC343780.1 | KC344022.1 | KC343296.1 | KC343538.1 |
| Diaporthe crataegi_CBS 114435 | KC343055.1 | KC343781.1 | KC344023.1 | KC343297.1 | KC343539.1 |
| Diaporthe crotalariae_CBS 162.33 | KC343056.1 | KC343782.1 | KC344024.1 | KC343298.1 | KC343540.1 |
| Diaporthe cuppatea_CBS 117499 | KC343057.1 | KC343783.1 | KC344025.1 | KC343299.1 | KC343541.1 |
| Diaporthe cynaroidis_CBS 122676 | KC343058.1 | KC343784.1 | KC344026.1 | KC343300.1 | KC343542.1 |
| Diaporthe decedens_CBS 109772 | KC343059.1 | KC343785.1 | KC344027.1 | KC343301.1 | KC343543.1 |
| Diaporthe decedens_CBS 114281 | KC343060.1 | KC343786.1 | KC344028.1 | KC343302.1 | KC343544.1 |
| Diaporthe detrusa_CBS 109770 | KC343061.1 | KC343787.1 | KC344029.1 | KC343303.1 | KC343545.1 |
| Diaporthe detrusa_CBS 114652 | KC343062.1 | KC343788.1 | KC344030.1 | KC343304.1 | KC343546.1 |
| Diaporthe elaeagni_CBS 504.72 | KC343064.1 | KC343790.1 | KC344032.1 | KC343306.1 | KC343548.1 |
| Diaporthe endophytica_CBS 133811 | KC343065.1 | KC343791.1 | KC344033.1 | KC343307.1 | KC343549.1 |
| Diaporthe endophytica_LGMF928 | KC343068.1 | KC343794.1 | KC344036.1 | KC343310.1 | KC343552.1 |
| Diaporthe eres_CBS 439.82 | KC343090.1 | KC343816.1 | KC344058.1 | KC343332.1 | KC343574.1 |
| Diaporthe eres_CBS 101742 | KC343073.1 | KC343799.1 | KC344041.1 | KC343315.1 | KC343557.1 |
| Diaporthe eres_CBS 109767 | KC343075.1 | KC343801.1 | KC344043.1 | KC343317.1 | KC343559.1 |
| Diaporthe cf. nobilis RG-2013_CBS 113470 | KC343146.1 | KC343872.1 | KC344114.1 | KC343388.1 | KC343630.1 |
| Diaporthe cf. nobilis RG-2013_CBS 116953 | KC343147.1 | KC343873.1 | KC344115.1 | KC343389.1 | KC343631.1 |
| Diaporthe cf. nobilis RG-2013_CBS 200.39 | KC343151.1 | KC343877.1 | KC344119.1 | KC343393.1 | KC343635.1 |
| Diaporthe eugeniae_CBS 444.82 | KC343098.1 | KC343824.1 | KC344066.1 | KC343340.1 | KC343582.1 |
| Diaporthe fibrosa_CBS 109751 | KC343099.1 | KC343825.1 | KC344067.1 | KC343341.1 | KC343583.1 |
| Diaporthe fibrosa_CBS 113830 | KC343100.1 | KC343826.1 | KC344068.1 | KC343342.1 | KC343584.1 |
| Diaporthe foeniculacea_CBS 123208 | KC343104.1 | KC343830.1 | KC344072.1 | KC343346.1 | KC343588.1 |
| Diaporthe foeniculacea_CBS 111553 | KC343101.1 | KC343827.1 | KC344069.1 | KC343349.1 | KC343585.1 |
| Diaporthe foeniculacea_CBS 187.27 | KC343107.1 | KC343833.1 | KC344075.1 | KC343343.1 | KC343591.1 |
| Diaporthe ganjae_CBS 180.91 | KC343112.1 | KC343838.1 | KC344080.1 | KC343354.1 | KC343596.1 |
| Diaporthe gardeniae_CBS 288.56 | KC343113.1 | KC343839.1 | KC344081.1 | KC343355.1 | KC343597.1 |
| Diaporthe helianthi_CBS 592.81 | KC343115.1 | KC343841.1 | KC344083.1 | KC343357.1 | KC343599.1 |
| Diaporthe helianthi_CBS 344.94 | KC343114.1 | KC343840.1 | KC344082.1 | KC343356.1 | KC343598.1 |
| Diaporthe hickoriae_CBS 145.26 | KC343118.1 | KC343844.1 | KC344086.1 | KC343360.1 | KC343602.1 |
| Diaporthe hongkongensis_CBS 115448 | KC343119.1 | KC343845.1 | KC344087.1 | KC343361.1 | KC343603.1 |
| Diaporthe hordei_CBS 481.92 | KC343120.1 | KC343846.1 | KC344088.1 | KC343362.1 | KC343604.1 |
| Diaporthe impulsa_CBS 114434 | KC343121.1 | KC343847.1 | KC344089.1 | KC343363.1 | KC343605.1 |
| Diaporthe impulsa_CBS 141.27 | KC343122.1 | KC343848.1 | KC344090.1 | KC343364.1 | KC343606.1 |
| Diaporthe inconspicua_LGMF922 | KC343124.1 | KC343849.1 | KC344091.1 | KC343365.1 | KC343607.1 |
| Diaporthe inconspicua_CBS 133813 | KC343123.1 | KC343850.1 | KC344092.1 | KC343366.1 | KC343608.1 |
| Diaporthe infecunda_CBS 133812 | KC343126.1 | KC343852.1 | KC344094.1 | KC343368.1 | KC343610.1 |
| Diaporthe infecunda_LGMF933 | KC343132.1 | KC343858.1 | KC344100.1 | KC343374.1 | KC343616.1 |
| Diaporthe longispora_CBS 194.36 | KC343135.1 | KC343861.1 | KC344103.1 | KC343377.1 | KC343619.1 |
| Diaporthe lusitanicae_CBS 123212 | KC343136.1 | KC343862.1 | KC344104.1 | KC343378.1 | KC343620.1 |
| Diaporthe lusitanicae_CBS 123213 | KC343137.1 | KC343863.1 | KC344105.1 | KC343379.1 | KC343621.1 |
| Diaporthe manihotia_CBS 505.76 | KC343138.1 | KC343864.1 | KC344106.1 | KC343380.1 | KC343622.1 |
| Diaporthe mayteni_CBS 133185 | KC343139.1 | KC343865.1 | KC344107.1 | KC343381.1 | KC343623.1 |
| Diaporthe megalospora_CBS 143.27 | KC343140.1 | KC343866.1 | KC344108.1 | KC343383.1 | KC343624.1 |
| Diaporthe melonis_CBS 507.78 | KC343142.1 | KC343868.1 | KC344110.1 | KC343384.1 | KC343626.1 |
| Diaporthe melonis_CBS 435.87 | KC343141.1 | KC343867.1 | KC344109.1 | KC343382.1 | KC343625.1 |
| Diaporthe musigena_CBS 129519 | KC343143.1 | KC343869.1 | KC344111.1 | KC343385.1 | KC343627.1 |
| Diaporthe neilliae_CBS 144.27 | KC343144.1 | KC343870.1 | KC344112.1 | KC343386.1 | KC343628.1 |
| Diaporthe neoarctii_CBS 109490 | KC343145.1 | KC343871.1 | KC344113.1 | KC343387.1 | KC343629.1 |
| Diaporthe nomurai_CBS 157.29 | KC343154.1 | KC343880.1 | KC344122.1 | KC343396.1 | KC343638.1 |
| Diaporthe novem_CBS 127270 | KC343156.1 | KC343882.1 | KC344124.1 | KC343398.1 | KC343640.1 |
| Diaporthe novem_CBS 354.71 | KC343158.1 | KC343884.1 | KC344126.1 | KC343400.1 | KC343642.1 |
| Diaporthe oncostoma_CBS 109741 | KC343161.1 | KC343887.1 | KC344129.1 | KC343403.1 | KC343645.1 |
| Diaporthe oncostoma_CBS 100454 | KC343160.1 | KC343886.1 | KC344128.1 | KC343402.1 | KC343644.1 |
| Diaporthe oxe_CBS 133186 | KC343164.1 | KC343890.1 | KC344132.1 | KC343406.1 | KC343648.1 |
| Diaporthe oxe_CBS 133187 | KC343165.1 | KC343891.1 | KC344133.1 | KC343407.1 | KC343649.1 |
| Diaporthe padi var. padi_CBS 114200 | KC343169.1 | KC343895.1 | KC344137.1 | KC343411.1 | KC343653.1 |
| Diaporthe padi var. padi_CBS 114649 | KC343170.1 | KC343896.1 | KC344138.1 | KC343412.1 | KC343654.1 |
| Diaporthe paranensis_CBS 133184 | KC343171.1 | KC343897.1 | KC344139.1 | KC343413.1 | KC343655.1 |
| Diaporthe perjuncta_CBS 109745 | KC343172.1 | KC343898.1 | KC344140.1 | KC343414.1 | KC343656.1 |
| Diaporthe perseae_CBS 151.73 | KC343173.1 | KC343899.1 | KC344141.1 | KC343415.1 | KC343657.1 |
| Diaporthe phaseolorum_CBS 116019 | KC343175.1 | KC343901.1 | KC344143.1 | KC343417.1 | KC343659.1 |
| Diaporthe phaseolorum_CBS 116020 | KC343176.1 | KC343902.1 | KC344144.1 | KC343418.1 | KC343660.1 |
| Diaporthe pseudomangiferae_CBS 101339 | KC343181.1 | KC343907.1 | KC344149.1 | KC343423.1 | KC343665.1 |
| Diaporthe pseudomangiferae_CBS 388.89 | KC343182.1 | KC343908.1 | KC344150.1 | KC343424.1 | KC343666.1 |
| Diaporthe pseudophoenicicola_CBS 462.69 | KC343184.1 | KC343910.1 | KC344152.1 | KC343426.1 | KC343668.1 |
| Diaporthe pseudophoenicicola_CBS 176.77 | KC343183.1 | KC343909.1 | KC344151.1 | KC343425.1 | KC343667.1 |
| Diaporthe pustulata_CBS 109784 | KC343187.1 | KC343913.1 | KC344155.1 | KC343429.1 | KC343671.1 |
| Diaporthe pustulata_CBS 109742 | KC343185.1 | KC343911.1 | KC344153.1 | KC343427.1 | KC343669.1 |
| Diaporthe raonikayaporum_CBS 133182 | KC343188.1 | KC343914.1 | KC344156.1 | KC343430.1 | KC343672.1 |
| Diaporthe rhoina_CBS 146.27 | KC343189.1 | KC343915.1 | KC344157.1 | KC343431.1 | KC343673.1 |
| Diaporthe saccarata_CBS 116311 | KC343190.1 | KC343916.1 | KC344158.1 | KC343432.1 | KC343674.1 |
| Diaporthe schini_CBS 133181 | KC343191.1 | KC343917.1 | KC344159.1 | KC343433.1 | KC343675.1 |
| Diaporthe schini_LGMF910 | KC343192.1 | KC343918.1 | KC344160.1 | KC343434.1 | KC343676.1 |
| Diaporthe sclerotioides_CBS 296.67 | KC343193.1 | KC343919.1 | KC344161.1 | KC343435.1 | KC343677.1 |
| Diaporthe sclerotioides_CBS 710.76 | KC343194.1 | KC343920.1 | KC344162.1 | KC343436.1 | KC343678.1 |
| Diaporthe scobina_CBS 251.38 | KC343195.1 | KC343921.1 | KC344163.1 | KC343437.1 | KC343679.1 |
| Diaporthe sojae_CBS 100.87 | KC343196.1 | KC343922.1 | KC344164.1 | KC343438.1 | KC343680.1 |
| Diaporthe longicolla isolate PL4 | HM347700.1 | HM347685.1 | KC344167.1 | KC343441.1 | KC343683.1 |
| Diaporthe sojae_CBS 116017 | KC343197.1 | KC343923.1 | KC344165.1 | KC343439.1 | KC343681.1 |
| Diaporthe sojae_CBS 180.55 | KC343200.1 | KC343926.1 | KC344168.1 | KC343442.1 | KC343684.1 |
| Diaporthe subordinaria_CBS 101711 | KC343213.1 | KC343938.1 | KC344180.1 | KC343454.1 | KC343696.1 |
| Diaporthe subordinaria_CBS 464.90 | KC343214.1 | KC343939.1 | KC344181.1 | KC343455.1 | KC343697.1 |
| Diaporthe tecomae_CBS 100547 | KC343215.1 | KC343940.1 | KC344182.1 | KC343456.1 | KC343698.1 |
| Diaporthe terebinthifolii_CBS 133180 | KC343216.1 | KC343941.1 | KC344184.1 | KC343457.1 | KC343699.1 |
| Diaporthe terebinthifolii_LGMF907 | KC343217.1 | KC343942.1 | KC344183.1 | KC343458.1 | KC343700.1 |
| Diaporthe toxica_CBS 534.93 | KC343220.1 | KC343943.1 | KC344185.1 | KC343459.1 | KC343701.1 |
| Diaporthe toxica_CBS 535.93 | KC343221.1 | KC343946.1 | KC344188.1 | KC343462.1 | KC343704.1 |
| Diaporthe vaccinii_CBS 160.32 | KC343228.1 | KC343947.1 | KC344189.1 | KC343463.1 | KC343705.1 |
| Diaporthe vaccinii_CBS 122112 | KC343224.1 | KC343954.1 | KC344196.1 | KC343470.1 | KC343712.1 |
| Diaporthe vexans_CBS 127.14 | KC343229.1 | KC343950.1 | KC344192.1 | KC343466.1 | KC343708.1 |
| Diaporthe rudis_CBS 113201 | KC343234.1 | KC343955.1 | KC344197.1 | KC343471.1 | KC343713.1 |
| Diaporthe rudis_CBS 109768 | KC343233.1 | KC343960.1 | KC344202.1 | KC343476.1 | KC343718.1 |
| Diaporthe woodii_CBS 558.93 | KC343244.1 | KC343959.1 | KC344201.1 | KC343475.1 | KC343717.1 |
| Diaporthe woolworthii_CBS 148.27 | KC343245.1 | KC343970.1 | KC344212.1 | KC343486.1 | KC343728.1 |
| Diaporthe cf. heveae 1 RG-2013_CBS 852.97 | KC343116.1 | KC343971.1 | KC344213.1 | KC343487.1 | KC343729.1 |
| Diaporthe cf. heveae 2 RG-2013_CBS 681.84 | KC343117.1 | KC343842.1 | KC344084.1 | KC343358.1 | KC343600.1 |
| Diaporthe sp. 1 RG-2013_CBS 119639 | KC343202.1 | KC343843.1 | KC344085.1 | KC343359.1 | KC343601.1 |
| Diaporthe sp. 1 RG-2013_LGMF947 | KC343203.1 | KC343928.1 | KC344170.1 | KC343444.1 | KC343686.1 |
| Diaporthe sp. 2 RG-2013_LGMF932 | KC343204.1 | KC343929.1 | KC344171.1 | KC343445.1 | KC343687.1 |
| Diaporthe sp. 3 RG-2013_CBS 287.29 | KC343205.1 | KC343930.1 | KC344172.1 | KC343446.1 | KC343688.1 |
| Diaporthe sp. 4 RG-2013_LGMF944 | KC343206.1 | KC343931.1 | KC344173.1 | KC343448.1 | KC343689.1 |
| Diaporthe sp. 5 RG-2013_CBS 125575 | KC343207.1 | KC343932.1 | KC344174.1 | KC343447.1 | KC343690.1 |
| Diaporthe sp. 6 RG-2013_CBS 115584 | KC343208.1 | KC343933.1 | KC344175.1 | KC343449.1 | KC343691.1 |
| Diaporthe sp. 6 RG-2013_CBS 115595 | KC343209.1 | KC343934.1 | KC344176.1 | KC343450.1 | KC343692.1 |
| Diaporthe sp. 7 RG-2013_CBS 458.78 | KC343210.1 | KC343935.1 | KC344177.1 | KC343451.1 | KC343693.1 |
| Diaporthe sp. 8 RG-2013_LGMF925 | KC343211.1 | KC343936.1 | KC344178.1 | KC343452.1 | KC343694.1 |
| Diaporthella corylina_CBS 121124 | KC343004.1 | KC343937.1 | KC344179.1 | KC343453.1 | KC343695.1 |
| Diaporthe stictica_CBS 370.54 | KC343212.1 | KC343730.1 | KC343972.1 | KC343246.1 | KC343488.1 |
| Pathogen | Day | FPYF3053 | FPYF3054 | FPYF3055 | FPYF3056 | ||||
|---|---|---|---|---|---|---|---|---|---|
| Percentage Inhibition | p-Value | Percentage Inhibition | p-Value | Percentage Inhibition | p-Value | Percentage Inhibition | p-Value | ||
| Alternaria alternata | 24 h | 28.77 ± 2.26 | 0.0003 | 41.41 ± 1.65 | 0.0001 | 37.68 ± 5.6 | 0.0078 | 34.51 ± 2.03 | 0.0002 |
| 48 h | 22.42 ± 2.34 | 0.0003 | 30.19 ± 1.56 | 0.0009 | 30.25 ± 5.12 | 0.0113 | 26.50 ± 3.42 | 0.0006 | |
| 72 h | 15.25 ± 2.59 | 0.0019 | 23.43 ± 2.27 | 0.0039 | 22 ± 4.03 | 0.0148 | 16.34 ± 2.36 | 0.0010 | |
| Botryosphaeria dothidea | 24 h | 46.3 ± 4.30 | 0.0030 | 50.17 ± 2.43 | 0.0006 | 43.74 ± 2.15 | 0.0000 | 37.88 ± 3.80 | 0.0002 |
| 48 h | 45.28 ± 2.63 | 0.0000 | 45.14 ± 2.35 | 0.0000 | 42.78 ± 0.43 | 0.0000 | 38.99 ± 0.98 | 0.0000 | |
| 72 h | NE * | ||||||||
| Botrytis cinerea | 24 h | 64.47 ± 1.05 | 0.0000 | 55.26 ± 4.82 | 0.0000 | 60.72 ± 1.91 | 0.0001 | 55.26 ± 4.71 | 0.0000 |
| 48 h | 50.42 ± 1.79 | 0.0000 | 35.02 ± 1.22 | 0.0000 | 39.44 ± 3.70 | 0.0000 | 32.41 ± 3.75 | 0.0003 | |
| 72 h | 36.55 ± 2.81 | 0.0000 | 24.27 ± 3.08 | 0.0001 | 30.10 ± 3.54 | 0.0005 | 24.25 ± 4.62 | 0.0025 | |
| Cercospora asparagi | 24 h | 31.46 ± 4.11 | 0.0003 | 22.64 ± 2.86 | 0.0074 | 23.21 ± 4.54 | 0.0202 | 18.57 ± 5.01 | 0.0086 |
| 48 h | 33.81 ± 2.97 | 0.0000 | 24.32 ± 2.21 | 0.0008 | 22.02 ± 2.96 | 0.0000 | 16.34 ± 1.53 | 0.0000 | |
| 72 h | 23.32 ± 2.17 | 0.0007 | 19.09 ± 2.73 | 0.0031 | 11.94 ± 3.54 | 0.0083 | 4.56 ± 0.85 | 0.0032 | |
| Colletotrichum gloeosporioides | 24 h | 26.83 ± 4.78 | 0.0153 | 9.75 ± 2.33 | 0.0009 | 10.68 ± 1.14 | 0.0001 | 10.74 ± 2.38 | 0.0229 |
| 48 h | 20.94 ± 3.33 | 0.0051 | 11.76 ± 2.35 | 0.0006 | 8.91 ± 1.24 | 0.0001 | 9.78 ± 2.36 | 0.0017 | |
| 72 h | 20.68 ± 1.56 | 0.0024 | 9.39 ± 2.78 | 0.0023 | 6.29 ± 0.80 | 0.0001 | 6.82 ± 2.01 | 0.0388 | |
| Fusarium graminearum | 24 h | 25.68 ± 1.13 | 0.0031 | 14.68 ± 2.05 | 0.0147 | 20.45 ± 3.62 | 0.0046 | 12.96 ± 1.42 | 0.0103 |
| 48 h | 29.99 ± 5.29 | 0.0086 | 12.9 ± 4.50 | 0.0284 | 31.12 ± 3.57 | 0.0203 | 21.59 ± 4.57 | 0.0425 | |
| 72 h | NE | ||||||||
| Phytophthora cinnamomi | 24 h | −5.01 ± 1.14 ** | 0.0029 | 19.21 ± 4.54 | 0.0036 | 31.02 ± 2.58 | 0.0001 | 8.38 ± 3.10 | 0.0154 |
| 48 h | −15.65 ± 6.36 | 0.0186 | 12.19 ± 3.30 | 0.0500 | 25.21 ± 4.29 | 0.0050 | 11.32 ± 4.22 | 0.0302 | |
| 72 h | −19.70 ± 4.19 | 0.0153 | 11.91 ± 2.12 | 0.0209 | 21.03 ± 2.80 | 0.0031 | 8.94 ± 2.03 | 0.0013 | |
| Sphaeropsis sapinea | 24 h | 23.39 ± 4.25 | 0.0147 | 22.69 ± 5.23 | 0.0239 | 21.84 ± 7.61 | 0.0491 | 7.41 ± 2.68 | 0.0364 |
| 48 h | 20.93 ± 1.04 | 0.0009 | 23.85 ± 1.68 | 0.0023 | 18.33 ± 5.22 | 0.0367 | 9.53 ± 0.60 | 0.0024 | |
| 72 h | NE | ||||||||
| Valsa sordida | 24 h | 5.96 ± 1.61 | 0.0115 | 9.73 ± 2.79 | 0.0014 | 5.14 ± 1.02 | 0.0153 | 3.15 ± 1.00 | 0.0177 |
| 48 h | NE | ||||||||
| 72 h | NE | ||||||||
| Retention Time (min) | Molecular Weight | Compound | Quality (%) a | Abundance (Relative) b | ||||||
|---|---|---|---|---|---|---|---|---|---|---|
| FPYF3053 | FPYF3054 | FPYF3055 | FPYF3056 | FPYF3053 | FPYF3054 | FPYF3055 | FPYF3056 | |||
| 6.17 | 106 | Ethylbenzene | 91.8 | 75.5 | 77.9 | 0.42 | 0.80 | 0.92 | ||
| 7.67 | 136 | α-Thujene | 91.9 | 89.3 | 89.8 | 30.57 | 37.10 | 36.19 | ||
| 9.88 | 136 | 1,3-Cyclohexadiene, 1-methyl-4-(1-methylethyl)- | 84.7 | 80.2 | 81.2 | 6.26 | 5.92 | 1.87 | ||
| 9.89 | 136 | 2-Carene | 86 | 84.9 | 1.80 | 6.20 | ||||
| 10.21 | 136 | α-Phellandrene | 74.9 | 78 | 0.74 | 5.15 | ||||
| 10.22 | 136 | β-Phellandrene | 88.4 | 90.9 | 75.2 | 87.7 | 12.55 | 56.07 | 2.35 | 18.70 |
| 10.92 | 136 | γ-Terpinene | 89.4 | 85.6 | 88.7 | 21.15 | 16.82 | 19.21 | ||
| 11.63 | 136 | Cyclohexene, 1-methyl-4-(1-methylethylidene)- | 81.1 | 1.66 | ||||||
| 11.89 | 154 | 2-Cyclohexen-1-ol, 1-methyl-4-(1-methylethyl)- | 81 | 0.65 | ||||||
| 12.29 | 152 | Unknown | 63.4 | 68.2 | 0.29 | 1.24 | ||||
| 12.3 | 152 | Thujone | 71.5 | 0.65 | ||||||
| 13.21 | 154 | l-Menthone | 90.4 | 27.91 | ||||||
| 13.68 | 156 | Cyclohexanol, 5-methyl-2-(1-methylethyl)- | 87.6 | 10.29 | ||||||
| 13.76 | 154 | 3-Cyclohexen-1-ol, 4-methyl-1-(1-methylethyl)-, (R)- | 88.5 | 89.7 | 85.6 | 5.53 | 22.38 | 5.88 | ||
| 13.91 | 208 | 2,4,4-Trimethyl-3-(3-methylbutyl)cyclohex-2-enone | 70.1 | 0.44 | ||||||
| 14.12 | 352 | Unknown | 66.3 | 0.28 | ||||||
| 14.13 | 240 | Unknown | 64.4 | 0.59 | ||||||
| 14.14 | 170 | Unknown | 64.9 | 1.35 | ||||||
| 17.42 | 388 | Unknown | 60.9 | 0.31 | ||||||
| 18.41 | 188 | Biphenylene, 1,2,3,6,7,8,8a,8b-octahydro-4,5-dimethyl- | 79 | 73.9 | 68.5 | 72.2 | 7.05 | 1.62 | 2.06 | 6.81 |
| 18.92 | 204 | Caryophyllene | 73.6 | 0.46 | ||||||
| 19.11 | 204 | Unknown | 69.7 | 0.31 | ||||||
| 19.74 | 204 | Patchoulene | 76.8 | 0.45 | ||||||
| 20.01 | 222 | Unknown | 63.1 | 0.41 | ||||||
| 20.13 | 204 | Cedrene | 78.2 | 1.11 | ||||||
| 20.46 | 204 | α-Muurolene | 92.2 | 81.1 | 81 | 81.6 | 11.54 | 2.51 | 3.17 | 2.26 |
| Pathogens | Percent Growth Inhibition | ||
|---|---|---|---|
| Phomopsis sp. EC-4 [17] * | Diaporthe Strain PR4 [18] | FPYF3053-3056 ** | |
| Aspergillus flavus | / *** | 34.6 | / |
| Aspergillus fumigatus | 57.0 ± 0.5 | / | / |
| Alternaria alternata | / | / | 30.25 ± 5.1~22.42 ± 2.3 |
| Botryosphaeria dothidea | / | / | 45.14 ± 2.4~25.28 ± 2.6 |
| Botrytis cinerea | 37.8 ± 0.5 | / | 50.42 ± 1.8~32.41 ± 3.8 |
| Ceratocystis fimbriata | / | 0.0 | / |
| Ceratocystis ulmi | 11.1 ± 1.5 | / | / |
| Cercospora asparagi | / | / | 33.81 ± 2.97~16.34 ± 1.5 |
| Cercospora beticola | 19.5 ± 0.5 | / | / |
| Colletotrichum sp. | / | / | 20.94 ± 3.3~8.91 ± 2.4 |
| Colletotrichum lagenarium | 0.0 | / | / |
| Fusarium oxysporum | / | 34.6 | 31.12 ± 3.6~12.9 ± 4.5 |
| Fusarium solani | 43.2 ± 0.00 | 16.6 | / |
| Geotrichum candidum, | 45.3 ± 0.5 | 57.0 | / |
| Trichoderma viride | 0.0 | / | / |
| Rhizoctonia solani | 53.0 ± 1.0 | 100 | / |
| Sphaerospsis sapinea | / | / | 23.85 ± 1.7~9.53 ± 0.6 |
| Sclerotinia sclerotiorum | 70.7 ± 1.1 | / | / |
| Valsa sordida | / | / | 9.73 ± 2.8~3.15 ± 1.00 |
| Verticillium dahliae | 19.4 ± 0.0 | 0.0 | / |
| Pythium ultimatum | 59.1 ± 0.9 | 13.3 | / |
| Phytophthora cinnamomi | 42.0 ± 0.5 | / | −19.70 ± 4.19~−5.01 ± 1.14, 25.21 ± 4.3~11.32 ± 4.2 |
| Phytophthora palmivora | 5.6 ± 0.5 | / | / |
© 2018 by the authors. Licensee MDPI, Basel, Switzerland. This article is an open access article distributed under the terms and conditions of the Creative Commons Attribution (CC BY) license (http://creativecommons.org/licenses/by/4.0/).
Share and Cite
Yan, D.-H.; Song, X.; Li, H.; Luo, T.; Dou, G.; Strobel, G. Antifungal Activities of Volatile Secondary Metabolites of Four Diaporthe Strains Isolated from Catharanthus roseus. J. Fungi 2018, 4, 65. https://doi.org/10.3390/jof4020065
Yan D-H, Song X, Li H, Luo T, Dou G, Strobel G. Antifungal Activities of Volatile Secondary Metabolites of Four Diaporthe Strains Isolated from Catharanthus roseus. Journal of Fungi. 2018; 4(2):65. https://doi.org/10.3390/jof4020065
Chicago/Turabian StyleYan, Dong-Hui, Xiaoyu Song, Hongchang Li, Tushou Luo, Guiming Dou, and Gary Strobel. 2018. "Antifungal Activities of Volatile Secondary Metabolites of Four Diaporthe Strains Isolated from Catharanthus roseus" Journal of Fungi 4, no. 2: 65. https://doi.org/10.3390/jof4020065
APA StyleYan, D.-H., Song, X., Li, H., Luo, T., Dou, G., & Strobel, G. (2018). Antifungal Activities of Volatile Secondary Metabolites of Four Diaporthe Strains Isolated from Catharanthus roseus. Journal of Fungi, 4(2), 65. https://doi.org/10.3390/jof4020065
